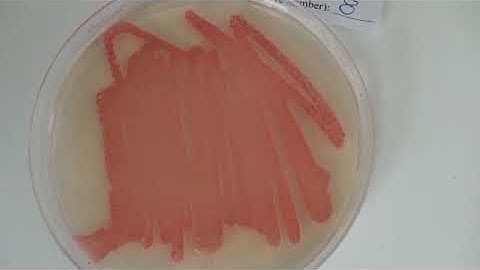
Simulation of an EPIDEMIC Results & Instructions

⬇ DOWNLOAD NOW
Kalau muncul iklan pop-up, tutup lalu klik tombol kembali
Download lagu Discussion of lab Epidemic Simulation secara gratis hanya untuk keperluan promosi. Dukung artis favorit kamu dengan membeli musik original di iTunes atau platform resmi lainnya.
 Lab Epidemic Simulation
Lab Epidemic Simulation
 Simulating an epidemic
Simulating an epidemic
 Epidemic, Endemic, and Eradication Simulations
Epidemic, Endemic, and Eradication Simulations
 epidemic simulation lab procedure
epidemic simulation lab procedure
Simulation of an EPIDEMIC Results & Instructions
Simulation of an EPIDEMIC Results & Instructions
 Simulation of epidemic
Simulation of epidemic
 Portrait of an Epidemic: Mathematical Modeling in Modern Day Epidemiology
Portrait of an Epidemic: Mathematical Modeling in Modern Day Epidemiology
 Computer Simulations to Enhance Vaccine Trials
Computer Simulations to Enhance Vaccine Trials